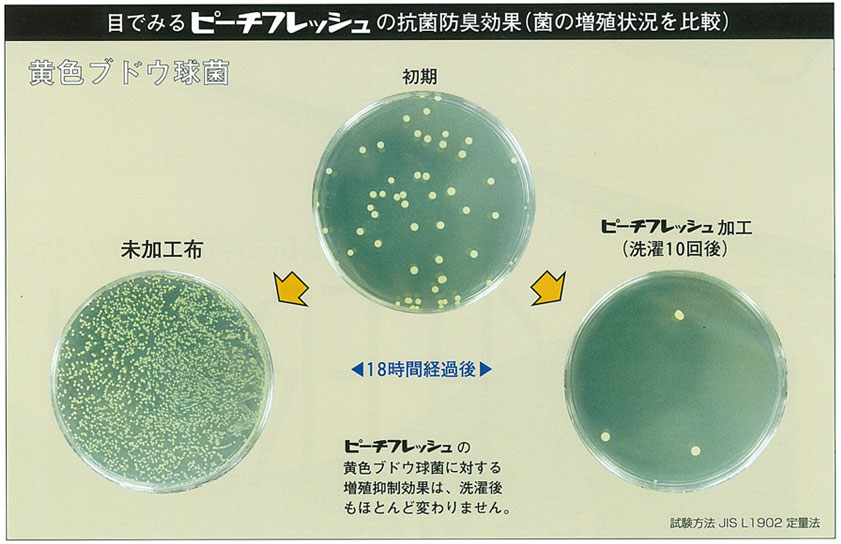
ピーチフレッシュの抗菌防臭効果

寝具別とカバーの相性
- キング
- 薄手のマットレス・敷き布団用
- 2重ガーゼ
- 抗菌防臭加工 SEK
- 日本製
汗のニオイを元からたつ!抗菌防臭加工ピーチフレッシュ加工済 ふわふわダブルガーゼ綿100%日本製 マットレスシーツ
- SEKマーク付きで安心の抗菌防臭加工済、ダブルガーゼ。
- ふわふわ綿100%ダブルガーゼは洗えば洗うほど柔らかくやさしい肌触り。
- ガーゼ素材はお肌に優しく、デリケートな肌の方にも安心してお使い頂けます。
- 素材について
-
ニオイの元をストップ!綿100%、抗菌防臭加工ピーチフレッシュ ダブルガーゼ
COTTON 100%
汗にニオイはありません!菌を増殖させないことがポイント
抗菌防臭加工の生地は一般的な平織りのものが多いのですが、通気性抜群の柔らかいふわふわダブルガーゼに抗菌防臭加工を施しました。汗臭の原因になる黄色ブドウ球菌の増殖を抑制し、汗のニオイの元からストップ!
汗そのものに臭いはほとんどありません。約20%の人の皮膚に存在するといわれる黄色ブドウ球菌などが、人間の皮膚に生息している菌が汗や皮脂を摂取し、排泄した分解物が悪臭の原因です。汗をかくということは、菌のエサが皮膚に増えることになるため、細菌が一気に増殖して「汗臭さ」になります。また、こうした細菌の腐敗した死骸も悪臭のもとです。
- POINT 01
-
安心の日清紡テキスタイル、ピーチフレッシュ
私たちは就寝中、毎日コップ1杯の汗をかきます。この汗を餌とし菌が繁殖して独特の汗臭が発生します。毎日洗えないカバーやシーツだからこそ、嬉しい加工です。

- POINT 02
-
安心の基準
抗菌防臭加工 SEKマーク(青)
ピーチフレッシュはSEKマークを取得しています。SEKマークとは、一般社団法人繊維評価技術協議会(JTETC)が実施する認証制度(業界自主基準)です。同協議会では、抗菌防臭加工を施した繊維製品の表示用語、評価方法・基準、安全性などに自主基準を設け、基準に合格した商品には「SEKマーク」を表示できるマーク制度を実施しています。


- POINT 03
-
洗えば洗うほどふわふわに
ガーゼは洗えば洗うほど、育っていくように、日々ふんわりさと柔らかさが増していくのを感じていただけます。赤ちゃんのおくるみなどにもよく使われるほど、ガーゼ素材はお肌に優しく、デリケートな肌の方、敏感肌の方にも安心してお使い頂けます。1度洗いでふわふわに。

- POINT 04
-
点結ガーゼで優れた通気性、
吸水性、吸湿性
2枚の綿100%ガーゼ生地をところどころ点で、結合して織られています。点結することで空気の通り道が多くでき、熱や汗を放出、通気性抜群です。また、2枚のガーゼ間に空気層ができ、ほどよい保温性があり夏はサラっと爽やかに、春秋もフワっとぬくもりを感じて頂ける年中使えるダブルガーゼカバーです。

あえての190本
密度を表す数値、スレッドカウント※の高い生地がいいというわけではありません。羽毛布団をお使いなのに、スレッドカウントの高い生地を使って羽毛がつぶれたり重すぎて快眠を妨げたりする場合もあります。この道70年以上の実績から生み出されたダブルガーゼは軽さと通気性をかねそなえた、ちょうどいいダブルガーゼになっています。
-

柔らかさを出す為あえて打ち込み本数190本
-

ホワイトなどの薄い色は若干の透け感があります。
※スレッドカウント (Thread count) は、生地の織り目の密度を示す用語で、1インチ=2.54cm 四方の布を織り上げるために使われた、横糸と縦糸を合計した糸の本数で表されます。織密度、打ち込み本数などとも呼ばれます。スレッドカウントの数値が高いと、布を織りあげるために、糸が多く使われ、織る密度が高くなり一般的には、滑らかさのある生地になります。
スタッフが使ってみました

STAFF
Aさん
- 身長:157cm /
家族構成:4人家族(夫・子供2人)
-
お洗濯すると
ふわふわになりました♪
息子が大好きなこのカバー。包みこまれているようなふわふわ感とブルーグレーの色が気に入った様子。汗かきなのでよく布団をけとばしているのですが、このカバーにしてからは通気性がいいせいか、朝にはきちんと布団をかぶっていることが多くなりました(笑)
- 染め・織り・加工
-
染め、織り、加工すべて日本で
MADE IN JAPAN

1枚1枚、職人が京都の自社工場で縫製
滋賀と京都に自社工場をもつ、創業70年岩本繊維。大手百貨店やインテリアショップ、寝具店へのカバーの卸し、ホテル等の館内着製造は年間10,000枚以上の多数販売実績がございます。原材料を輸入、染、織、加工縫製をすべて日本国内で行っているカバー専門店です。

-
- 素材の企画、商品開発、製造、出荷まで一貫して行っています
- つくるカバーで使用する生地はほぼ全て織り、染めも日本で行った国産生地で、全て京都の自社工場で縫製しています。生地の開発、お客さまのご要望にきめこまかく対応し製造、出荷、アフターサービスまで一貫で行い責任をもつことで、お届けする商品には自信をもっております。自分たちの目の届くところで商品を作り、品質管理をし、改善を続けて参ります。
海外製と違う、濁りのない
発色と繊細な加工

-
- つくるカバーでは、快眠に最適なコットン、リネン、シルクなどの天然素材のみを厳選し、さらに肌触りのよい生地にこだわっています。生地はほぼ全てオリジナルで、織りから、染め、仕上げ加工まで日本国内のものがほとんどです。直接、現地工場に足を運び、各分野のエキスパートに「こんなことできないか」と相談しながら生地を企画することもしばしば。とことん心地よい生地を追求しています。
- カラー
-
やわらかい質感とやさしい色合い
6 COLOR

ガーゼならではの柔らかさと明るいお色目で若い方にも人気のシリーズ。ダブルガーゼ特有のふわふわした質感でお色も均一に見えず、どのカラーもふっくらとした優しいイメージです。
-
ホワイト(6701)

染色していない晒のホワイト。敷き寝具のカバーでは一番人気のお色目です
-
ミルク(6702)

やわらかいミルキーなアイボリーは、ガーゼとの相性バツグン
-
ピンク(6703)

青みがちなピンクは、清潔感さえただよう、すっきりした桜色
-
ブルーグレー(6704)

人気のブルーグレーはデニムのような明るいブルー
-
モカブラウン(6705)

ダーク感をおさえ、ファミリーでも使いやすい明るいモカ
-
グレー(6706)

どの色とも相性バツグンなグレー。一点投入するだけでおしゃれになるから不思議です
- 商品詳細
-
ピーチフレッシュダブルガーゼ(品番:6700)
PEACHFRESH DOUBLEGAUZE PRODUCT
| アイテム |
マットレスシーツ マチつきシーツ キング /キングロング/キングスーパーロング |
| 寸法 |
幅:180~199×丈:181~250cm |
| 素材 |
綿100% ダブルガーゼ 無地 / 日清紡テキスタイルピーチフレッシュ加工 |
| 番手 / 打込本数 |
40番手 / 190本 |
| 仕様 |
裏面のゴム(選択:天地、全周)
継ぎ目は幅151cm以上から入ります |
| カラー |
ホワイト(6701) / ミルク(6702) / ピンク(6703) / ブルーグレー(6704) / モカブラウン(6705) / グレー(6706) |
| 寸法変化率 |
タテ-3%、ヨコ-3%(※洗濯方法や取扱いによって収縮率はこの限りではございません。心配な方は収縮率を目安に大きいサイズをご指定頂くのがおすすめです) |
| 重量/厚み |
846g(掛布団カバー シングル 150×210cm)0.45mm |
| 生産国 |
織り:大分/染め・加工:大阪/縫製:京都 |
- 注意事項
-
- 本商品はご注文を受けてから1枚ずつ隣接する自社工場でお作りするオーダーメイド商品(受注生産品)です。
- 「製造開始」してからの、お客様ご都合によるキャンセル・返品交換はお受け致しかねます。サイズ・色をお間違えのないようご確認下さい。
- ご注文直後で製造開始前のキャンセル・変更はお電話またはメールにてお受け致します。
- 商品のお色につきましては、ご利用されるモニター、OSによっても、実際の商品の色が多少異なってみえる場合がございます。ご心配な方は生地サンプルをお取り寄せ下さい。
- 仕様変更は事前の告知なく変更する場合がございます。予めご了承下さい。
- 生地ロットによっては色ブレや風合いが異なる場合がございます。
-
シーツの縫製について
幅151cm以上のご注文の場合は、片側にハギが入ります。

ご注意!151cm以上の大きいサイズには、継ぎ目(ハギ)がでます
日本での織、染、加工にこだわったオリジナル生地を使用しておりますので、生地巾が150cm以下となってしまうため、151cm以上のシーツやカバーをお作りする場合には、継ぎ目(ハギ)が入ってしまいます。通常は生地のロスが少ない継ぎ目でお作りしますが、お使い頂く用途によって、継ぎ目を指定していただくことも可能です。
- マットレスシーツサイズ表(敷き布団・マットレスのサイズから選ぶ)
-

つくるカバーのセミオーダーメイド
幅、丈、高さなどのサイズ、
裏面のゴムまで自由自在
つくるカバーで使用する生地はほぼ全て織り、染めも日本で行った国産生地で、全て京都の自社工場で縫製しています。在庫はもたず、ご注文頂いてから1点1点職人がお作りするので、サイズはもちろん、細かな仕様まで自由自在のカスタマイズできます。今お持ちの布団にぴったりのあなた好みのカバーをお作りいたします。
- 自分だけのオリジナルカバーを簡単カスタマイズ
- マットレスシーツ セミオーダーメニュー
長さ、高さをかえられる
-
- 01.
- 幅をかえる

1cm単位で幅をかえられます
(選択必須)
詳細はこちら
-
- 02.
- 丈をかえる

1cm単位で丈をかえられます
(選択必須)
詳細はこちら
-
- 03.
- 高さをかえる

1cm単位で高さをかえられます
(選択必須)
詳細はこちら
長さ、色をかえられる
-
01. 幅をかえる
選択必須項目、サイズアップは有料です
敷き布団やマットレスの品質表示タグのサイズ通りに選択肢をお選びください。(選択肢は必ずお選びください)タグ表記がなかったり、サイズの計測が必要な場合はこちらをご参考になさってください。

-

品質表示タグをご確認ください
-

端から端までを直線距離で 計測してください
-
02. 丈をかえる
選択必須項目、サイズアップは有料です
敷き布団やマットレスの品質表示タグのサイズ通りに選択肢をお選びください。(選択肢は必ずお選びください)タグ表記がなかったり、サイズの計測が必要な場合はこちらをご参考になさってください。

-

品質表示タグをご確認ください
-

端から端までを直線距離で計測して下さい
-
03. 高さをかえる
選択必須項目、サイズアップは有料です
敷き布団やマットレスの品質表示タグのサイズ通りに選択肢をお選びください。(選択肢は必ずお選びください)タグ表記がなかったり、サイズの計測が必要な場合はこちらをご参考になさってください。

-

品質表示タグをご確認ください
-

なるべくへたっていない端の部分を計測してください
-
04. 裏面のゴムをかえる
有料サービス、未選択の場合は天地ゴムで縫製します
マットレスを出し入れする裏面のゴムの位置をかえられます。
種類によって一部有料となります。マットレスの種類やご使用
方法によってゴムの種類をお選びください。
-

通常は天地(頭と足の部分)にゴムがつきます(無料)
両サイドはゴムが入らず、ほぼ生地はかかりません
-

据え置きタイプ(折りたたまないマットレス)
には全周ゴム(ぐるり1周)がつきます(有料)
-

天地ゴムはマットレスの折り曲げる場所にゴムが
入っていないので三つ折りしやすく、カバーも傷め
ないため三つ折りマットレスに最適です
-

全周ゴムは裏側のふちすべてにゴムが入るため、
カバーがはずれにくくなています。
- お洗濯・耐久性について
-
じゃぶじゃぶ洗っても大丈夫
MACHINE WASHABLE
お洗濯方法


- 洗濯機で丸洗い可能(30度以下弱水流)
- 直射日光のあたらない吊り干しにして下さい。
- 乾燥機、漂白剤のご使用はお避け下さい。
- 汗や雨、お洗濯時に濡れたままにしておきますと色移りすることがあります。
引き裂き強度が証明する安心の耐久性
固くなりすぎず、耐久性を損なわない程度の厚みで、一般的な綿ブロードと同じくらいの強度です。ご家庭の洗濯機でもじゃぶじゃぶ洗えます。

引き裂き強度はタテ33.3N、ヨコ23.8N
一般的な綿ブロード生地(8N)の3倍以上丈夫
※タンブラー乾燥の試験データはあくまでこの生地の品質を評価するためのものになりますので、ご家庭でのタンブラー乾燥はお控えください。
| 引き裂き強度比較(単位:ニュートン) |
| 綿ブロード |
タテ 7.5N / ヨコ 6.3N |
| シングルガーゼ |
タテ 13.2N / ヨコ 11.1N |
| ダブルガーゼ |
タテ 39.3N / ヨコ 22.3N |
くらべてみました(10回洗濯後)
お客様からのお問い合わせが多い洗濯後の変化です。色褪せ、表面変化、縮みぐあいです。
カラー:掛布団カバー シングル ピンク
- 表面変化
- (毛玉、毛羽立ちぐあい)
-

【新品】
新品時はしっかりした感触です
-

【10回洗濯後】
洗えば洗うほどふっくらと、毛玉も見当たりません
- 縮み
- 45×90cmの枕カバーを10回洗濯後(吊り影干しにて約24時間: 冬場)